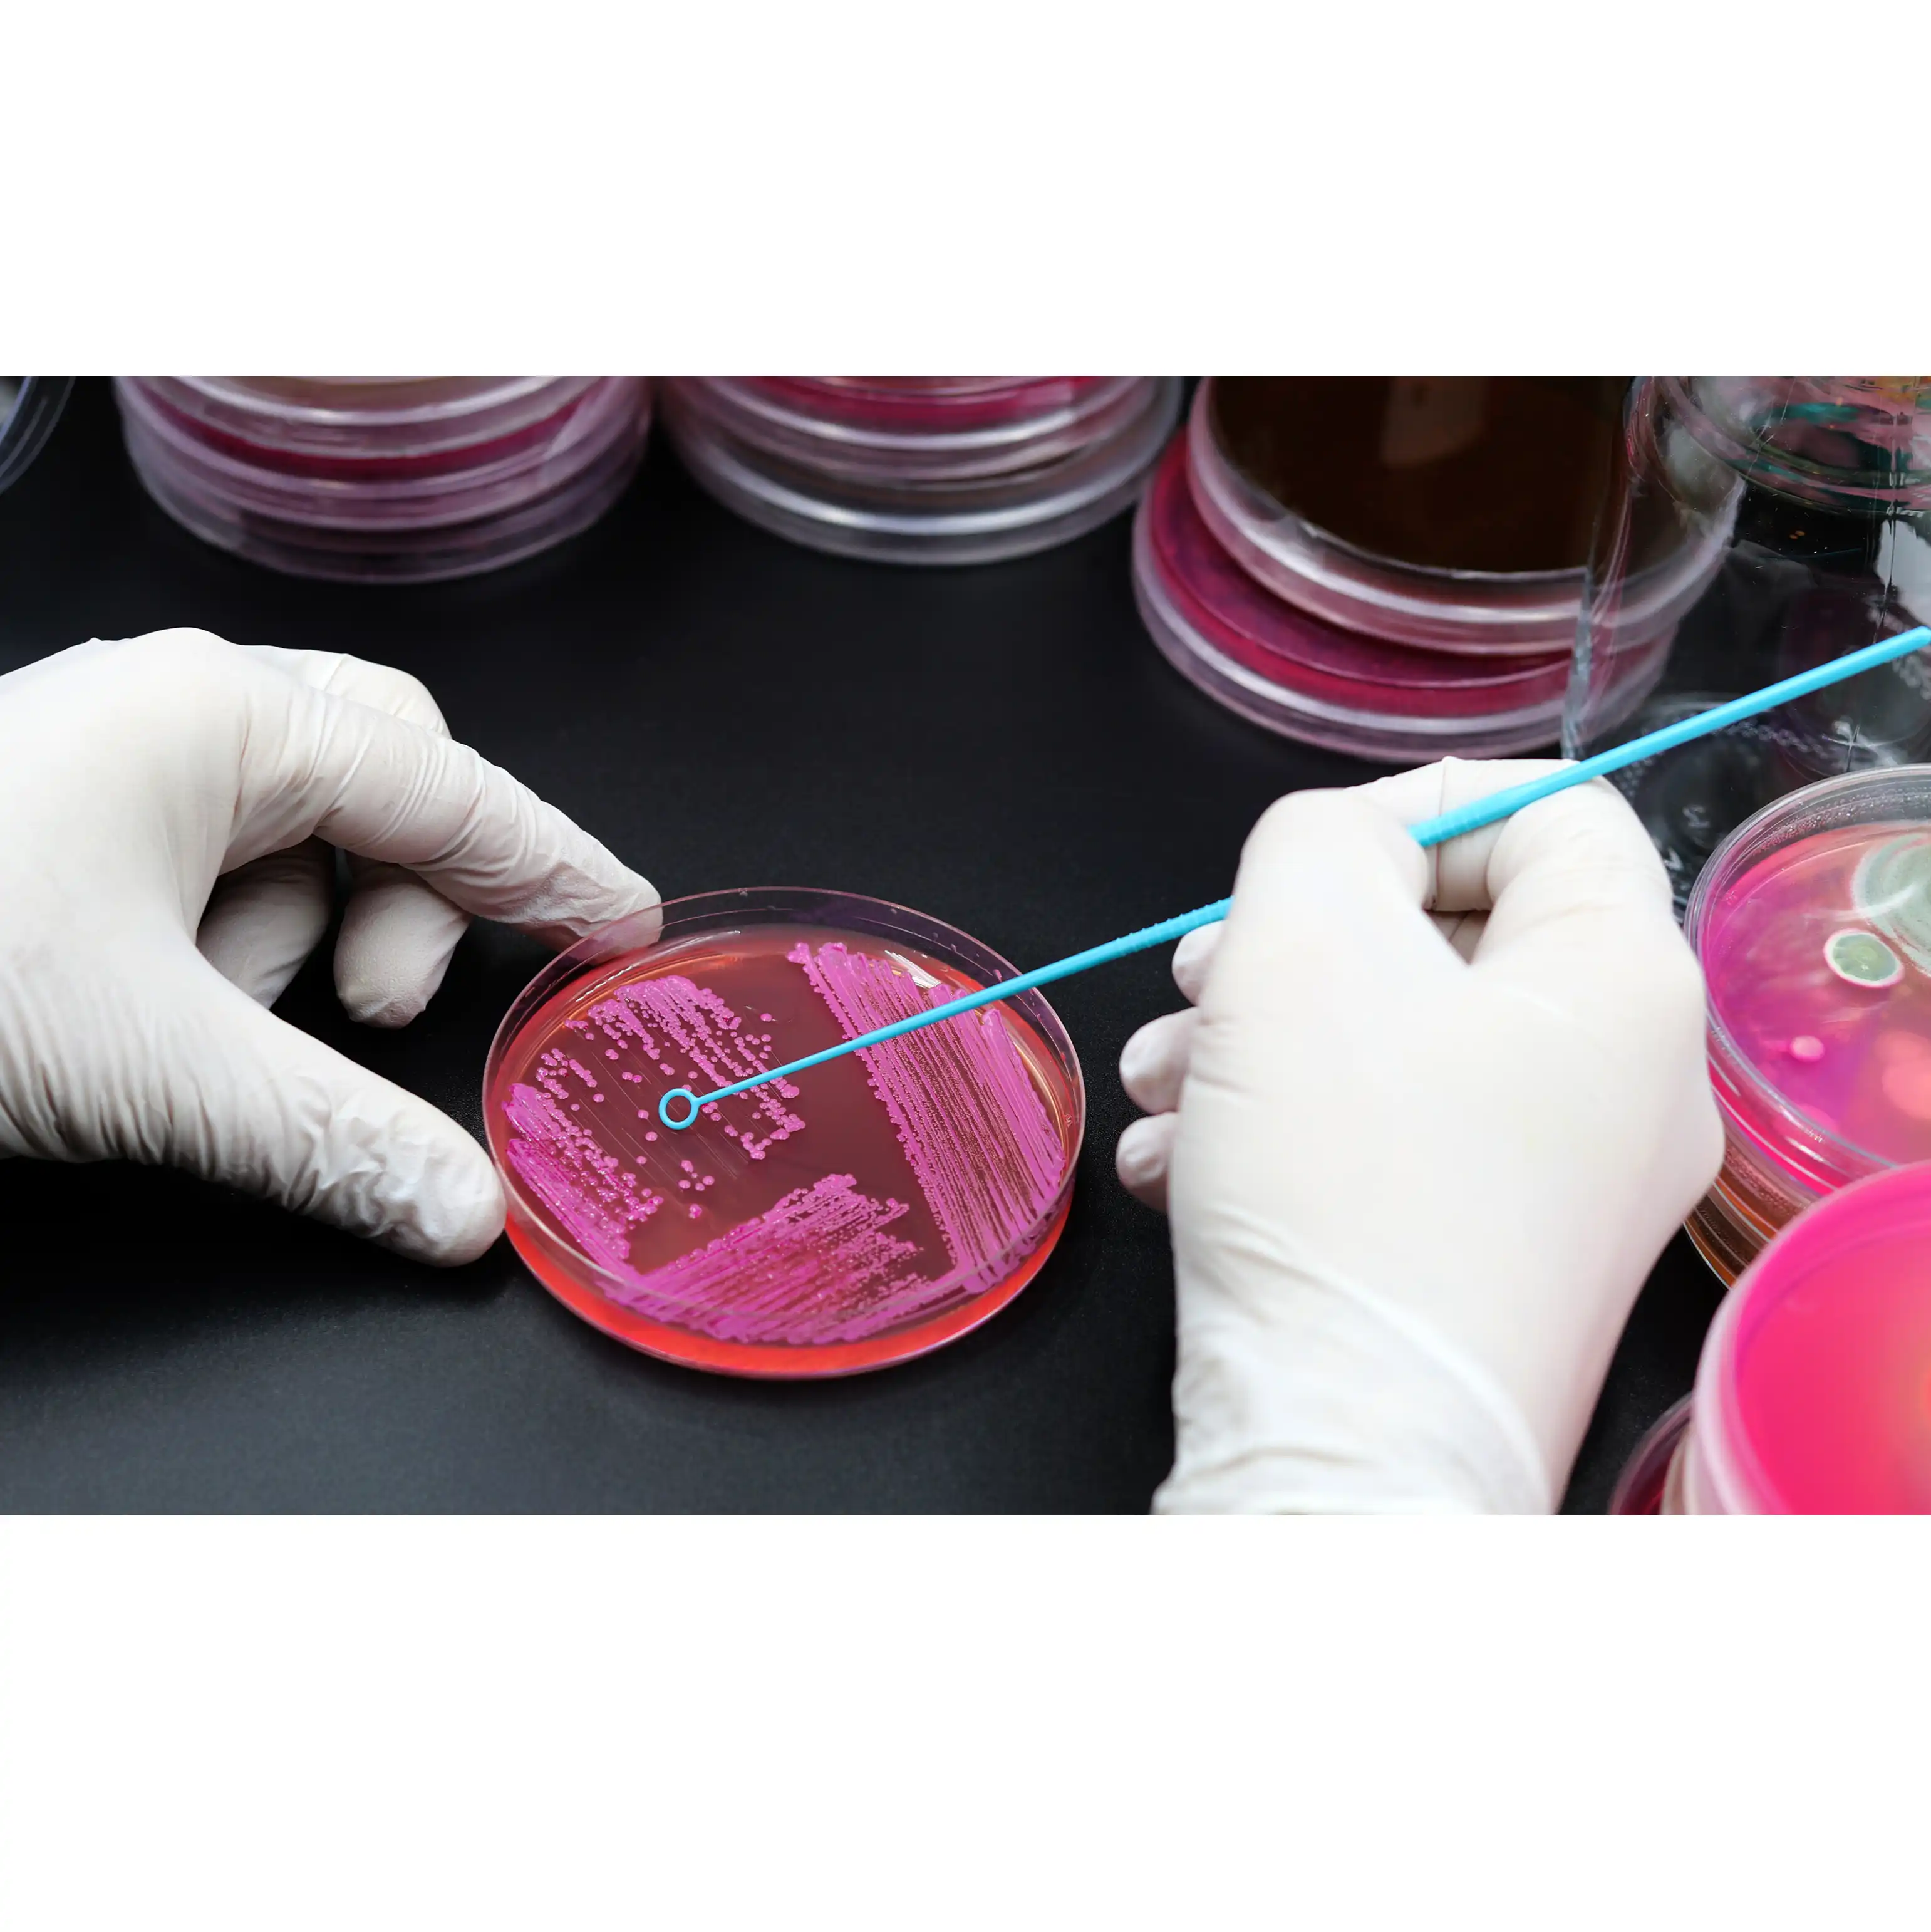

Shaymaa Waleed
FOCUS ASCP and Clinical Lab Tutor
Preparing for the ASCP MLS/MLT exams is a vital step in your medical laboratory career. As a seasoned tutor and certified professional, I offer personalized, one-on-one tutoring designed to meet your specific goals. With customized study plans, effective test strategies, and a focus on mastering essential concepts, I am committed to helping you excel. Work with me to build your confidence, deepen your knowledge, and achieve your certification goals.
In addition, I offer small group tutoring sessions, accommodating 3 to 4 students.
Start your journey to becoming ASCP certified with the guidance of an expert!